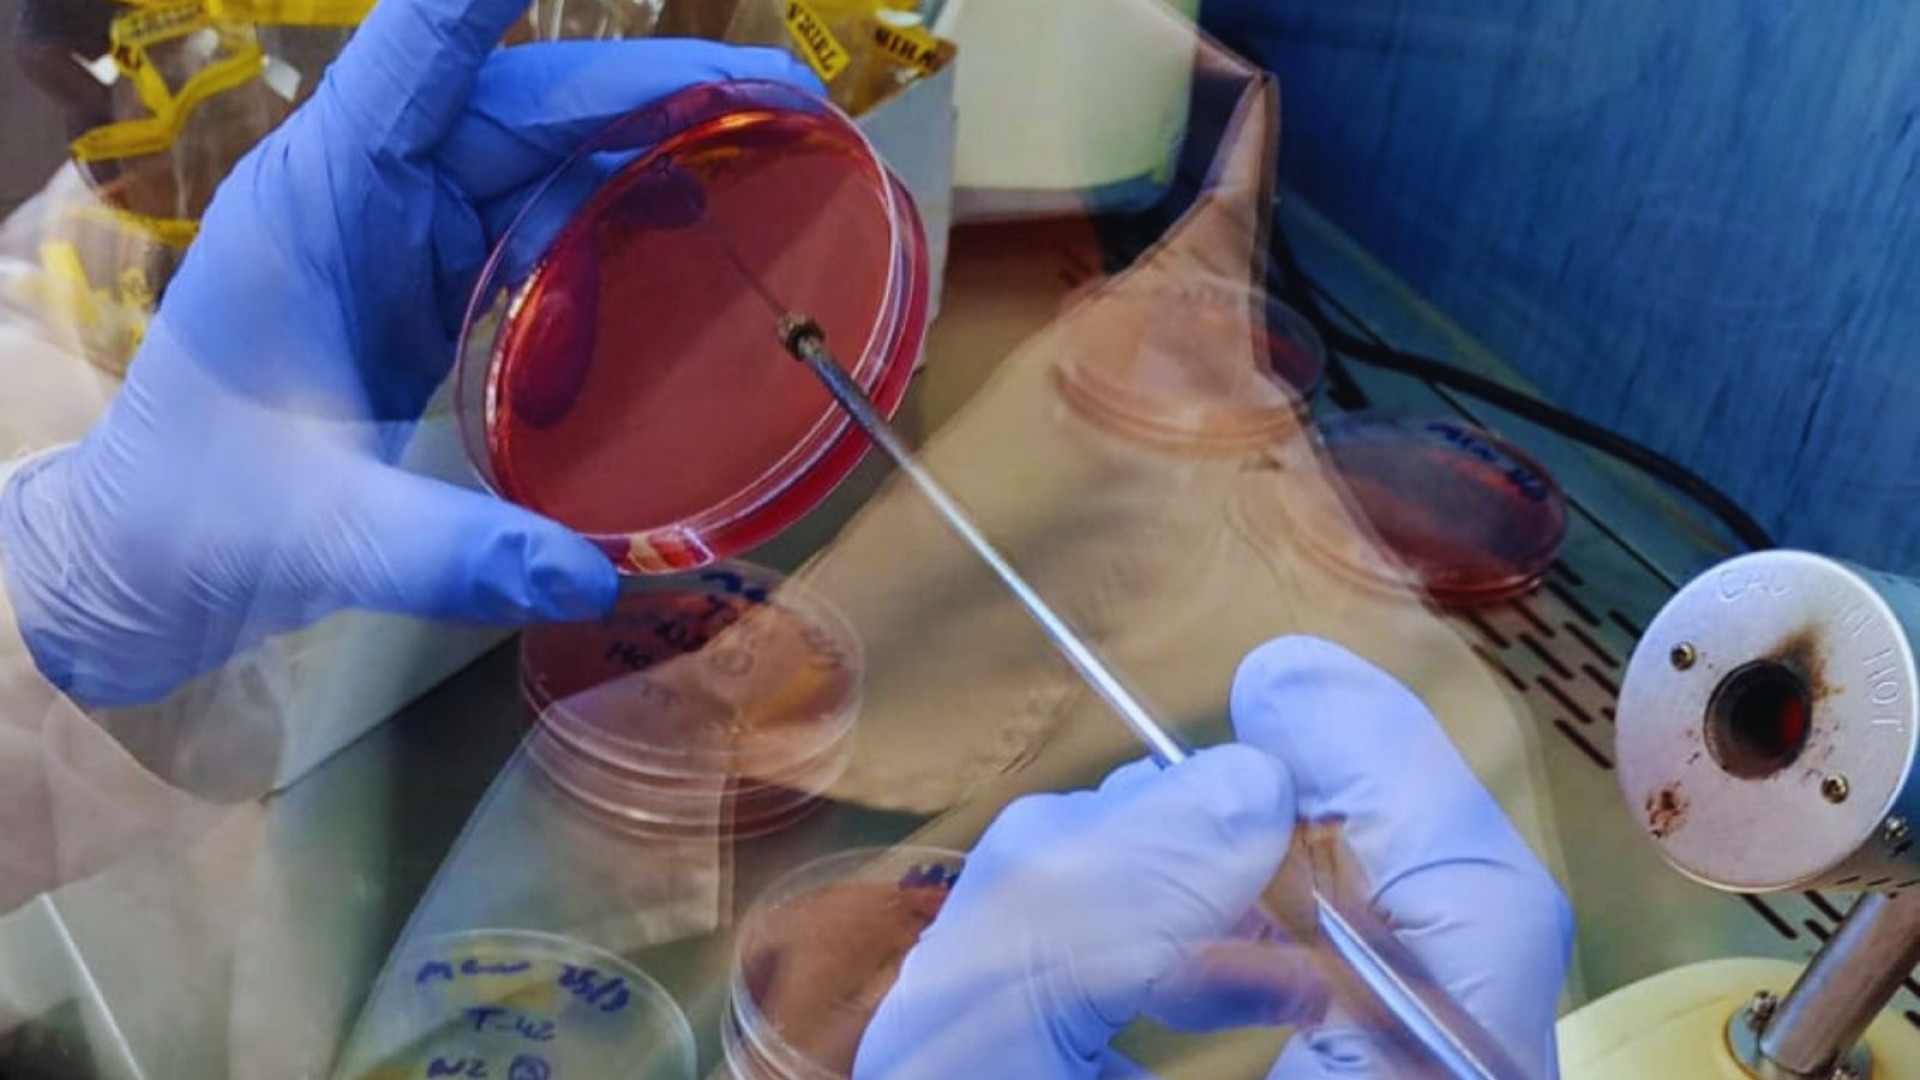

07:38 Hs 27/03/2026 El Gobierno del Chaco, a través del Instituto Chaqueño de Ciencia, Tecnología e Innovación (ICCTI), anunció la realización de la 3ª edición de la Cumbre Chaqueña de Ciencia, Tecnología e Innovación, que tendrá lugar el próximo viernes 10 de abril, de 8 a 17 horas, en el Centro de Convenciones Gala.
06:20 Hs 27/03/2026 La Unidad de Investigación Avícola (UIA) del INTA Concepción del Uruguay fue incorporada oficialmente a la Red Nacional de Laboratorios del Senasa (RedLab). Este paso garantiza análisis con validez oficial y estándares de calidad homogéneos. En esta primera etapa, quedó habilitado para la detección de Salmonella spp.

Foto de archivo - Pescare
06:18 Hs 27/03/2026 Se trata del Bao Feng que fue multado por detección electrónica. Se consolida así el nuevo paradigma de control pesquero nacional.

10:54 Hs 27/03/2026 El Virus Sincicial Respiratorio (VSR) es una de las principales causas de bronquiolitis y hospitalización en lactantes menores de un año en Argentina. La inclusión de la vacunación materna en el calendario nacional es un avance significativo, sin embargo, persiste una brecha de protección que afecta a miles de bebés vulnerables durante la temporada de mayor circulación viral.

La joven catalana padecía dolores irreversibles desde 2022 y había mantenido una larga batalla judicial con su padre.
06:42 Hs 27/03/2026 La española Noelia Castillo Ramos, de 25 años, murió este jueves luego de recibir la eutanasia en una residencia sociosanitaria de Sant Pere de Ribes, en Cataluña, tras casi dos años de conflictos judiciales con su padre para impedir el procedimiento. Su caso se convirtió en uno de los más polémicos desde la aprobación de la ley de muerte asistida en España.
.jpg)
06:28 Hs 27/03/2026 El índice de los salarios creció un 2,5% en enero, aunque se mantuvo por debajo del Índice de Precios al Consumidor (IPC) de ese mismo periodo, que fue del 2,9%.

06:05 Hs 26/03/2026 La abogada argentina Agostina Páez deberá esperar para volver a la Argentina hasta que la Justicia brasileña dicte una resolución definitiva tras condenarla a dos años de prisión suspenso por el delito de injuria racial.

06:58 Hs 26/03/2026 El Gobierno Nacional avanza en la privatización de la empresa estatal Intercargo, dedicada a los servicios de rampa en los aeropuertos del país, e informó las condiciones de venta.

06:54 Hs 26/03/2026 Confederaciones Rurales Argentinas afirmó que hay indignación en el sector por la "desprotección estructural del interior productivo". "Quienes vivimos en el campo recorremos hoy nuestros establecimientos con una inseguridad creciente", se quejó.
.jpg)
06:49 Hs 26/03/2026 Tras una primera jornada tensa, acompañada por protestas en la calle, la audiencia por la reforma a la Ley de Glaciares se reanudará este jueves con una nueva reunión, en este caso virtual, que recogerá las voces de expositores de todo el país.
.jpg)
La planta principal de La Serenísima, empresa ahora adquirida por Arcor y Danone.
06:40 Hs 25/03/2026 Grupo Arcor y Danone anunciaron este martes una alianza estratégica en Argentina que incluye la adquisición conjunta del 51% restante de Mastellone Hermanos y la creación de un joint venture para consolidar el negocio lácteo en el país.
.jpg)
06:07 Hs 25/03/2026 El sistema financiero creció casi 25% y, junto al sector energético y al agro, fueron los de mejor desempeño. La economía creció 4,4%, pero a menor ritmo desde el proceso electoral.

09:03 Hs 24/03/2026 La única empresa fabricante de aisladores eléctricos del país cerró sus puertas y trajo preocupación en el sector, ya que era la que abastecía a gran parte del mercado.
06:02 Hs 27/03/2026 La Cámara Argentina de Comercio y Servicios (CAC), la Confederación Argentina de la Mediana Empresa (CAME), la Unión de Entidades Comerciales Argentinas (UDECA) y la Federación Argentina de Empleados de Comercio y Servicios (FAECyS) firmaron un nuevo acuerdo paritario para la actividad mercantil, con una suba salarial del 5%.
06:56 Hs 27/03/2026 El Programa de Atención Médica Integral (PAMI) restableció la cobertura del 100% en medicamentos para jubilados y pensionados en todo el país, luego de una resolución judicial vinculada a los criterios de acceso vigentes durante los últimos meses.
06:32 Hs 27/03/2026 Estudiantes de La Plata fue inhibido por la FIFA y quedó impedido de registrar refuerzos mientras no resuelva una deuda con Inter Miami relacionada con la transferencia de Facundo Farías.
06:21 Hs 26/03/2026 El jefe de Gabinete, Manuel Adorni, anunció este mediodía el avance en la concesión por 30 años de la histórica Unidad Turística Chapadmalal, ubicada al sur de la ciudad de Mar del Plata, en el marco de la política oficial de reducir la participación del Estado en distintos sectores.
06:01 Hs 26/03/2026 La Senadora Nacional Patricia Bullrich afirmó que la familia de Agostina Páez atraviesa un momento de “desesperación” y denunció que dirigentes políticos habrían condicionado gestiones vinculadas al caso a cambio de un reconocimiento público.
06:56 Hs 26/03/2026 El Jefe de Gabinete, Manuel Adorni, habría adquirido un departamento en el barrio porteño de Caballito sin desprenderse de la propiedad en la que residía previamente en Parque Chacabuco, según registros oficiales del Registro de la Propiedad Inmueble.
06:51 Hs 26/03/2026 La Auditoría General de la Nación (AGN) avanza en una auditoría sobre la Administración Nacional de Medicamentos, Alimentos y Tecnología Médica (ANMAT) en la causa por fentanilo contaminado y se espera que este jueves 26 de marzo familiares de víctimas asistan a un taller de planificación participativa para definir los pasos a seguir.
06:39 Hs 26/03/2026 En los dos últimos años creció la producción, pero empeoraron los indicadores laborales. La principal explicación a esta paradoja son las trabas que impone el entorno regulatorio a la generación de empleo. Para dinamizar el mercado de trabajo se necesita darle continuidad al proceso de reformas estructurales.
07:09 Hs 25/03/2026 Agostina Páez se presentó ante la Justicia en Río de Janeiro y quedó habilitada a regresar a la Argentina, donde deberá cumplir tareas comunitarias. Dijo sentir alivio, aunque reconoció que siente temor por la situación vivida.
06:19 Hs 24/03/2026 La participación fue alta: casi 59%. La propuesta fue vista por muchos ciudadanos como una amenaza a la independencia judicial.
06:57 Hs 24/03/2026 El periodista y autor de "El Avión" analizó en Cadena 3 la intención política detrás del feriado nacional y cuestionó el "relato" que oculta la violencia previa al golpe de 1976.

| Mercado | Actual | Anterior | Var% |
| Rosario |
| Mercado | Actual | Anterior | Var% |
| Rosario | 2655 |
| Mercado | Actual | Anterior | Var% |
| Rosario | 1725 |
| Mercado | Actual | Anterior | Var% |
| Rosario |


Sorteo del dia: 27/03/2026

